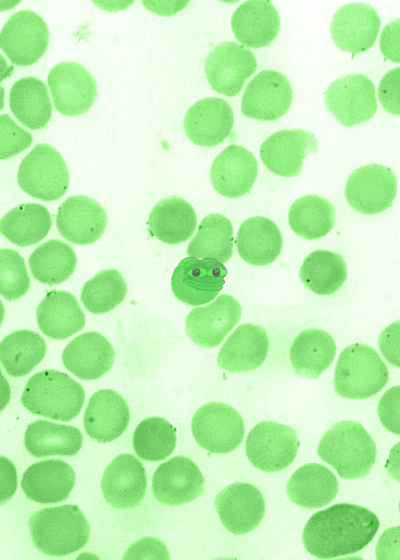

Btc: $76,588 -0.8% | Btc Block Height: 951,097 | XCP: $1.27 -2.1% | PEPECASH: 0.0015XCP | BITROCK: 0.0000005BTC | BITCORN: 0.01155XCP | DANKROSECASH: 0.0000009BTC | KEVIN src20: $0.000700 | STAMP src20: $0.012029 | FAKEASF: 0.01BTC | CORB: 0.037BTC |